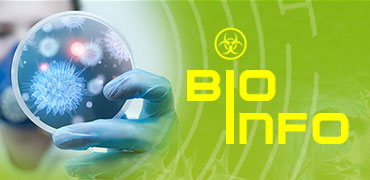

Bazy wiedzy z zakresu BHP

Pierwsza Pomoc
– Serwis nt. pierwszej pomocy
w nagłych wypadkach
BioInfo
- Baza wiedzy o zagrożeniach biologicznych

ChemPył - Baza wiedzy o zagrożeniach chemicznych
i pyłowych

Poważne
awarie przemysłowe

BEZPIECZNIEJ
- Profilaktyka zagrożeń środowiskowych









